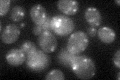
YEL048C
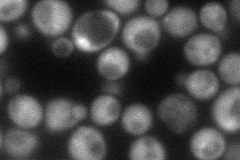
YEL048C
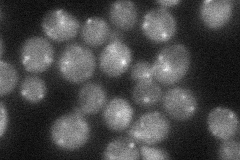
YEL048C
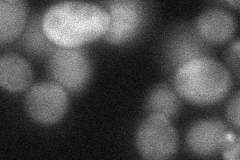
YEL048C
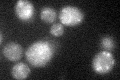
YEL048C
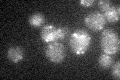
YEL048C

View description
Protein that interacts with subunits of the TRAPP complex and may play a role its assembly or stability; mutation is synthetically lethal with gcs1 deletion; Sedlin_N family member; human Sedlin mutations cause the skeletal disorder SEDT
Localization:
Intensity:
Fold change:
Significance:
-
C’ GFP library in SD
punctate33.51 -
N' NOP1pr-GFP in SD
cytosol,punctate75.5283 -
N' TEF2pr-mCherry in SD

cytosol148.473 -
N' NATIVEpr-GFP in SD
punctate36.5454 -
N' TEF2pr-VC and Cyto-VN in SD
cytosol39.2177 -
C’ GFP library in SD+DTT
punctate24.810.74No -
C’ GFP library in SD+H2O2

punctate29.610.88No -
C’ GFP library in Starvation Media
punctate19.570.58Yes -
C’ GFP library on the background of Pup2-DaMP

punctate -
C’ GFP library on the background of CCT mutant

punctate30.68670.915333No
